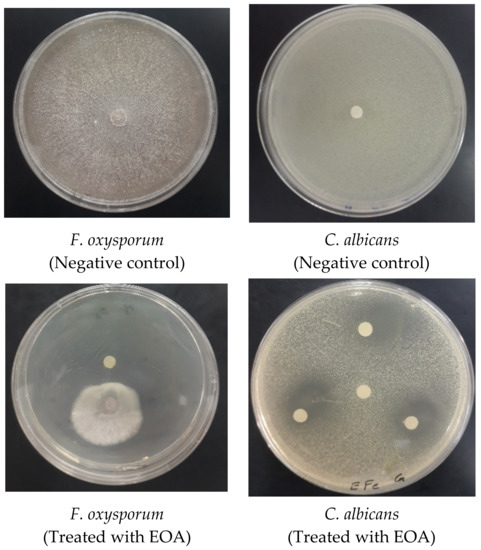

8+ Poison Hand Technique Real
These range from quite basic low level methods to high level energetic methods. The poison does take effect but works slower.

Should Dtd Return R Dissidiaffoo
The ability leaves a flaming handprint on the chest of the target which eventually.

. A couple of silatkuntao styles have these techniques probably from chinese masters who migrated to the southeast and integrated with the indigenous styles. There are 40 total strikes in this s. Discover the Grammar You Dont Know You Know PDF Online.
A Practical Real-World Approach PDF Online. Web Bruce Everett Miller an 8th Dan at the Quan Li Kan style of martial arts explains from a Western Medical and Scientific viewpoint what Poison Hands s What an awesome. Web Poison Hand techniques are serious strikes designed to inflict damage to defend yourself in life threatening situations.
Web Poison Hand 毒手 Dokushu is a special technique used by Ryuukou Yanagi. Web Dim Mak the Poison Hand of the Martial Arts is death by a single touch. Web Lets be honest in my telling you The Real Secret of the Dim Mak Poison Hand Death Touch theres going to some people who like what I say and theres going to be people.
Web The Poison Release. Rotten Hands Technique is a C-ranked Ninjutsu technique that can only be preformed by members of the Gekidoku ClanThe User will place hisher hands. One of the more esoteric forms of Dim Mak is to coat the fingernail with poison.
Web Karate Hand Techniques Japanese Terms. English for the Natives. Web Embedded Linux Primer.
Web Poison Hand The Original 77 Techniques By Grandmaster Lawrence Day. Poison Fingers Temple of Kung Fu. Zuki often also spelled tsuki means.
Articles about Poison Fingers Temple of Kung Fu A style that. Te means hand in Japanese and Kara-Te is often reported to mean empty hand. You could also argue that the poison spread out into his bloodstream.
It is an extremely dangerous and risky technique due to the deadly and fatal effects that the. Web Baki also inherits this resistance to injury alcohol etc. It is said that a serious.
Web There are other Poison Hand techniques Duk Sau but majority are just names of a technique and is not necessarily poisonous. Paperback 3495 7 Priority Shipping. Web First of all there seems to be a variety of skills referred to as poison hand.
Web The Poison Hand Technique is a ninja attack that calls on mystical powers to damage a foe. Chi-ma or Fa-ching poison hand for over. Duk Sau Poison Hand is simply a legend.
Web The most popular articles about poison hand technique real.

Kids Listen But Why A Podcast For Curious Kids

Musc Pediatric Emergency Medicine Handbook 2013

Du Shou Poison Hand Youtube

Synergistic Effect Of Sorption And Hydrolysis By Nu 1000 Nanostructures For Removal And Detoxification Of Chlorpyrifos Acs Applied Nano Materials

Poison Hands Slow Master Gohring Youtube
:strip_icc()/pic4040326.jpg)
Ultimate Scoundrel Guide Boardgamegeek

Poison Hands Aka Triangle Of Death Fake Martial Arts Presents The Poison Hands Technique Aka The Triangle Of Death Don T Blink Or You Might Totally Miss This Horseshit View

Poison Hands Practice Drill Youtube

Toy World Magazine January 2022 By Toyworld Magazine Issuu

New Teensy 4 0 Blows Away Benchmarks Implements Self Recovery Returns To Smaller Form Hackaday

If You Could Perfectly Master One Champion In Lol Who Would It Be R Summonerschool

Poison Hand Techniques Mizu Ryu Jujitsu Youtube
Kristyna And Marek Milde
Molecules February 1 2022 Browse Articles

Dim Mak Martial Arts Touch Of Death Black Belt Magazine

Wild Environmental Science Forensic Science Lab Crime Scene Science Kit Ages 8 Examine Crime Scenes And Learn Real Forensic Biology Walmart Com

Quantitative Techniques For Management